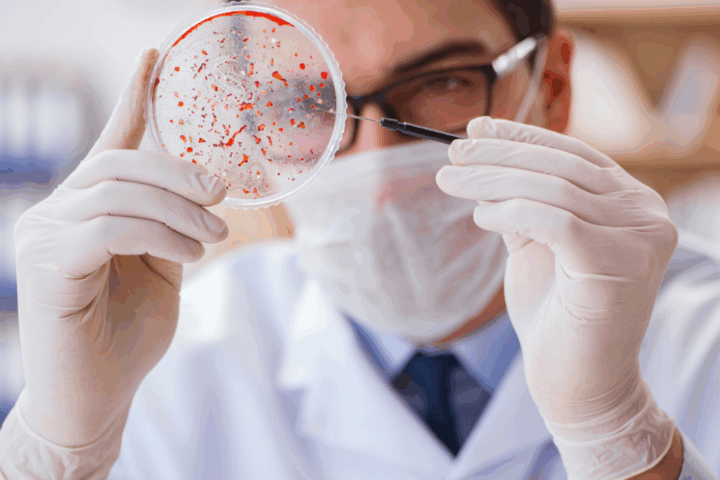

La combinación de calor y polen durante la primavera puede desencadenar problemas cutáneos en personas con piel delicada

Una experta recomienda protegerse del sol utilizando cremas solares y cubriendo el cuerpo con ropa
La llegada de la primavera supone un desafío particular para quienes tienen la piel sensible, advierte la doctora Trinidad Montero, responsable de la Unidad de Dermatitis Atópica del Hospital Universitario Virgen de las Nieves de Granada y miembro del Colegio Ibero-Latinoamericano de Dermatología (CILAD).
Montero señala que durante esta estación, la mayor exposición a los rayos solares y a irritantes como el polen convierte la primavera en un período de «rojeces y picor» para quienes sufren este tipo de afecciones cutáneas.
«Durante la primavera, las personas pasan más tiempo al aire libre. Con más horas de sol, la gente tiende a salir más, usar menos ropa, lo que agrava enfermedades cutáneas sensibles a la radiación ultravioleta, como el lupus o la rosácea. Además, con la floración de plantas, aumentan las dermatitis de contacto alérgicas e irritativas debido al polen. Y, además, al estar más expuesta la piel al sol, también se incrementan las picaduras de insectos», explica la doctora Montero.
Exposición prolongada al sol y polen
De este modo, cuanto más tiempo de exposición al sol una hora más a partir del domingo 31, más complicaciones para las enfermedades que se ven agravadas por sus radiaciones. Además, todos aquellos que tienen la piel más sensible por ejemplo, por una dermatitis atópica que ya tiene alterada la función de barrera de su piel también van a sufrir hipersensibilidad ante ese polen y ante ese ambiente que favorece el desarrollo de enfermedades alérgicas.
«El cambio de hora hace que estemos más expuestos a la radiación ultravioleta. Pero lo determinante son esas condiciones que aparecen con el cambio de temperatura y que facilitan la aparición de lesiones relacionadas con el sol, como quemaduras, hiperpigmentación de la piel e, incluso, picaduras de insectos», afirma la doctora.
Desafíos primaverales para la piel sensible
Además, en las ciudades, en las que debido a la contaminación hay mayor prevalencia de esa dermatitis de contacto alérgica, la tormenta puede llegar a ser aún más fuerte que en las zonas rurales en las que, paradójicamente, florecen más plantas. «El polen va a favorecer el desarrollo de esas dermatitis de contacto alérgica en la gente que está sensibilizada y a alentar la aparición de lesiones también en zonas de piel más sensibles, como los párpados y las regiones periorificiales alrededor de la boca, ojos y nariz] con rojeces y sensación de picor y quemazón», explica la especialista.
Una primera medida para evitar estos efectos sería protegerse del sol, utilizando cremas solares y cubriendo el cuerpo con ropa, gorra o sombrero, e incluso unas gafas de sol, que podrían hacer de barrera para evitar el contacto con alérgenos, especialmente los párpados, que son una zona muy sensible, recomienda Montero, que también considera prioritario consultar a un especialista.
En cuanto al tratamiento, «dependerá del tipo de patología». Si el paciente tiene una lesión de base, como puede ser un lupus o una rosácea, lo más indicado sería protegerse del sol para evitar que empeore y luego ya, dependiendo de la patología de la que se trate, pues ponerle un tratamiento adecuado», concluye la dermatóloga.